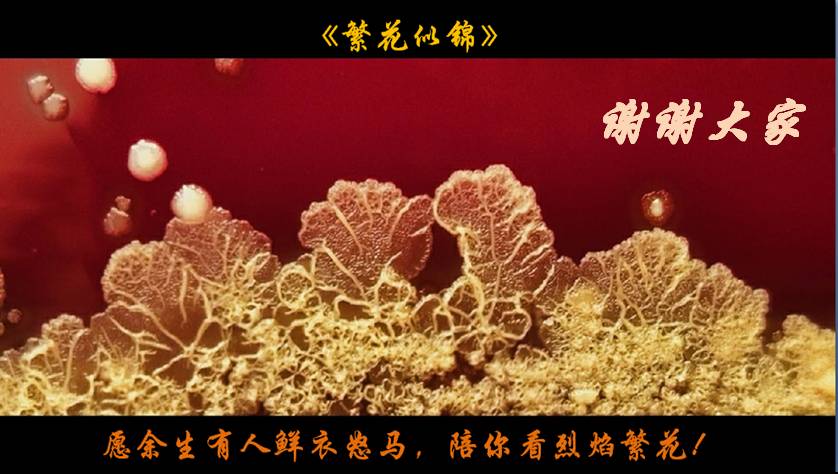

2018PIDMIC >为何只见“沙门美女”不见“志贺君”?
为何只见“沙门美女”不见“志贺君”?

白雅红 陕西省宝鸡市人民医院
副主任检验师,从事微生物检验工作八年余,非常热爱微生物工作,尤其热衷微生物形态学摄影,摄影作品多次荣获奖项,撰写论文五篇,参与《医学真菌学》书籍的编写,参与市级课题两项,经常撰写一些网络美图美文。